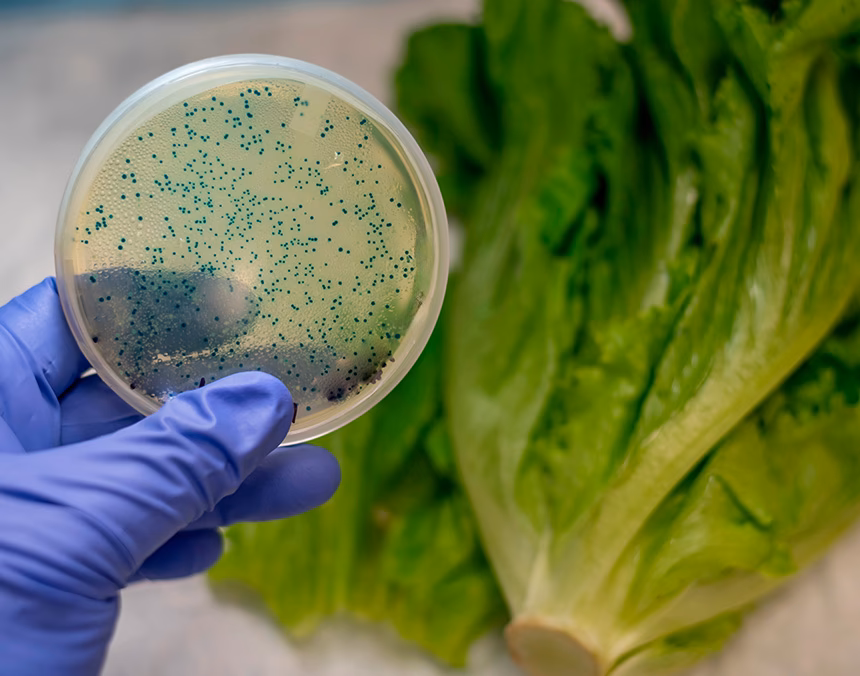
¿Cómo prevenir el cólera?

05/01/2010
En el vasto y complejo universo de nuestros océanos, existen microorganismos que juegan un papel fundamental en el equilibrio de los ecosistemas marinos. Sin embargo, algunos de estos, bajo ciertas condiciones, pueden representar un serio riesgo para la salud humana. Uno de los géneros de bacterias más notorios en este sentido es Vibrio, un habitante natural de las aguas costeras que, debido al calentamiento global y los cambios en nuestros mares, está ganando cada vez más protagonismo. Este artículo profundiza en qué es la bacteria Vibrio, cómo se detecta, los riesgos que implica y, lo más importante, cómo la salud de nuestros océanos está intrínsecamente ligada a nuestra propia salud.

¿Qué es la Bacteria Vibrio y Dónde se Encuentra?
Vibrio es un género de bacterias gramnegativas que se encuentran de forma natural en ambientes acuáticos, especialmente en aguas saladas y salobres como estuarios, deltas y zonas costeras. Son organismos halófilos, lo que significa que prosperan en presencia de sal. Aunque existen muchas especies de Vibrio, tres de ellas son particularmente preocupantes para la salud pública:
- Vibrio cholerae: El agente causante del cólera, una enfermedad diarreica aguda que puede ser mortal si no se trata.
- Vibrio parahaemolyticus: Una causa común de gastroenteritis asociada al consumo de mariscos crudos o poco cocidos.
- Vibrio vulnificus: A menudo apodada la "bacteria carnívora", puede causar infecciones graves en heridas y septicemia (infección en la sangre) potencialmente mortal, sobre todo en personas con sistemas inmunitarios debilitados.
Estas bacterias proliferan en aguas cálidas, generalmente por encima de los 20°C. Por esta razón, las infecciones por Vibrio, conocidas genéricamente como vibriosis, son mucho más comunes durante los meses de verano. El aumento de las temperaturas globales está expandiendo el hábitat geográfico y la ventana temporal en la que estas bacterias pueden florecer, convirtiéndolas en una creciente amenaza ambiental y de salud.
Vías de Transmisión: El Puente entre el Océano y Nosotros
La infección por Vibrio no se transmite de persona a persona. El contagio siempre ocurre a través del contacto con su medio natural. Las dos vías principales de infección son:
- Consumo de Mariscos Contaminados: Esta es la causa más común de vibriosis. Los mariscos bivalvos como las ostras, almejas y mejillones son filtradores. Al alimentarse, filtran grandes volúmenes de agua y pueden acumular bacterias Vibrio en sus tejidos en concentraciones mucho más altas que las del agua circundante. Consumir estos mariscos crudos o poco cocidos es una ruta directa para que la bacteria ingrese a nuestro sistema digestivo.
- Exposición de Heridas Abiertas: La bacteria puede ingresar al cuerpo a través de cualquier ruptura en la piel, ya sea un corte, un rasguño, una quemadura o incluso un tatuaje reciente. Nadar o caminar en aguas costeras cálidas contaminadas con una herida abierta puede derivar en una infección cutánea que, en el caso de Vibrio vulnificus, puede evolucionar rápidamente a una fascitis necrotizante, destruyendo el tejido de la piel y los músculos.
Pruebas y Diagnóstico: ¿Cómo se Detecta la Presencia de Vibrio?
Cuando un paciente presenta síntomas compatibles con la vibriosis, especialmente si ha consumido mariscos crudos recientemente o ha estado en contacto con agua de mar teniendo una herida, los médicos inician un proceso de diagnóstico para confirmar la presencia de la bacteria. La detección es crucial para iniciar un tratamiento adecuado y rápido.
Las pruebas que se pueden realizar incluyen:
- Cultivo de Muestras: Es el método estándar. Dependiendo de los síntomas, el médico tomará una muestra de heces, de la herida o de sangre. Esta muestra se coloca en un medio de cultivo especial (como el agar TCBS - Tiosulfato-Citrato-Bilis-Sacarosa) que favorece el crecimiento de las bacterias Vibrio e inhibe el de otras. Si las colonias de Vibrio crecen, se pueden realizar pruebas bioquímicas adicionales para identificar la especie exacta.
- Pruebas de Reacción en Cadena de la Polimerasa (PCR): Son métodos moleculares mucho más rápidos y específicos. La PCR puede detectar el material genético (ADN) de la bacteria Vibrio directamente en la muestra del paciente. Esto permite una identificación en cuestión de horas en lugar de días, lo cual es vital en casos de infecciones graves como la septicemia por V. vulnificus.
- Análisis de Sangre: En casos de sospecha de septicemia, un hemocultivo es fundamental. Se extrae sangre del paciente para cultivarla y verificar si las bacterias han invadido el torrente sanguíneo.
Es fundamental que el paciente informe al profesional de la salud sobre cualquier exposición reciente a ambientes marinos o consumo de mariscos, ya que esta información orienta el diagnóstico y la elección de las pruebas adecuadas.
Síntomas y Riesgos: De una Molestia a una Emergencia Médica
Los síntomas de la vibriosis varían según la vía de entrada y la especie de Vibrio implicada.
Tabla Comparativa de Infecciones por Vibrio
| Tipo de Infección | Vía de Contagio Principal | Síntomas Clave | Especie Común |
|---|---|---|---|
| Gastroenteritis (Vibriosis) | Consumo de mariscos crudos | Diarrea acuosa, calambres abdominales, náuseas, vómitos, fiebre, escalofríos. | V. parahaemolyticus |
| Infección de Herida | Contacto de herida con agua contaminada | Enrojecimiento, dolor intenso, hinchazón, ampollas, úlceras, posible fascitis necrotizante. | V. vulnificus |
| Septicemia | Consumo de mariscos (en grupos de riesgo) o herida grave | Fiebre alta, escalofríos, descenso de la presión arterial (shock séptico), lesiones cutáneas ampollosas. | V. vulnificus |
Aunque la mayoría de las personas sanas que contraen vibriosis gastrointestinal se recuperan en unos pocos días, ciertos grupos de personas tienen un riesgo mucho mayor de desarrollar complicaciones graves. Las personas con enfermedades hepáticas crónicas (como cirrosis o hepatitis), diabetes, cáncer, VIH o cualquier condición que debilite el sistema inmunitario son extremadamente vulnerables a que la infección se propague al torrente sanguíneo, una condición que tiene una alta tasa de mortalidad.
Prevención: Nuestra Mejor Defensa
La prevención es la herramienta más eficaz contra la vibriosis. Implica tanto una responsabilidad personal como una conciencia sobre la salud de nuestros ecosistemas marinos. Las siguientes medidas pueden reducir drásticamente el riesgo:
- Cocina bien los mariscos: No comas ostras u otros mariscos crudos o poco cocidos. La cocción a temperaturas adecuadas mata las bacterias Vibrio.
- Evita la contaminación cruzada: Mantén los mariscos crudos separados de los alimentos cocidos. Lávate las manos, las tablas de cortar y los utensilios con agua y jabón después de manipular mariscos crudos.
- Protege tus heridas: Evita nadar en agua salada o salobre si tienes una herida abierta. Si no puedes evitarlo, cubre la herida con un vendaje impermeable.
- Limpia las heridas inmediatamente: Si sufres un corte mientras estás en el agua o manipulas mariscos crudos, lávalo a fondo con agua limpia y jabón.
- Presta atención tras eventos climáticos: Después de huracanes o inundaciones costeras, las concentraciones de Vibrio en el agua pueden aumentar. Ten especial precaución en estas situaciones.
Preguntas Frecuentes (FAQ)
¿Es seguro nadar en el mar?
Para la mayoría de las personas sanas y sin heridas abiertas, nadar en el mar es seguro. El riesgo aumenta significativamente si tienes cortes, rasguños o un sistema inmunitario debilitado. La clave es la precaución y conocer tu estado de salud.
¿El limón o la salsa picante matan a la bacteria Vibrio en las ostras crudas?
No. Esto es un mito muy extendido. Ni el jugo de limón, ni la salsa picante, ni el alcohol son suficientes para matar a las bacterias Vibrio. La única forma segura de eliminarlas es mediante una cocción adecuada.
¿El cambio climático está empeorando el problema de Vibrio?
Sí. El cambio climático está calentando las aguas de los océanos, lo que permite que las bacterias Vibrio sobrevivan y se multipliquen en áreas geográficas más amplias y durante períodos más largos del año. Esto aumenta la probabilidad de exposición humana.
¿Qué tratamiento existe para la vibriosis?
Para casos leves de gastroenteritis, el tratamiento se centra en la rehidratación. Para infecciones de heridas o casos graves, se administran antibióticos (como doxiciclina o ciprofloxacino). En el caso de infecciones necrotizantes, a menudo es necesaria una intervención quirúrgica para retirar el tejido muerto y detener el avance de la infección.
En conclusión, la bacteria Vibrio es un recordatorio tangible de que nuestra salud está indisolublemente ligada a la del planeta. A medida que las temperaturas del océano continúan aumentando, la amenaza de patógenos como Vibrio se volverá más presente. La conciencia, la educación y las prácticas seguras son fundamentales para coexistir con estos habitantes naturales de nuestros mares, protegiendo tanto nuestra salud como la de los valiosos ecosistemas marinos de los que dependemos.
Si quieres conocer otros artículos parecidos a Vibrio: El riesgo oculto en aguas cálidas puedes visitar la categoría Medioambiente.
